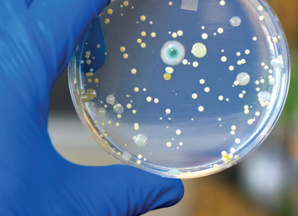
Plaidoyer pour la synergie des approches sanitaires Plaidoyer pour la synergie des approches sanitaires

Apparu au début des années 2000, le concept « One Health » - une seule santé - résume en deux mots une notion connue depuis plus d’un siècle, à savoir que la santé humaine et la santé animale sont interdépendantes et liées à la santé des écosystèmes dans lesquels elles coexistent. Dans le contexte d’une année 2020 marquée par une pandémie issue d’un virus qui a muté pour passer d’un animal vers l’Homme, la Journée mondiale de « One Health », célébrée le 3 novembre 2020, prend une importance particulière puisqu’elle vise à promouvoir une approche dont la finalité est justement de prévenir les catastrophes sanitaires. Au Maroc, cette Journée a été marquée par l’organisation d’une visioconférence sur la thématique « l’approche One Health sous l’ère du Covid-19 ».
Diverses perspectives
La table ronde virtuelle organisée par l’association « One Health Maroc » a été ainsi animée par des intervenants issus de divers domaines concernés par ce concept, avec, entre autres, Maryam Bigdeli, représentante de l’Organisation Mondiale de la Santé (OMS) au Maroc, Laila El Ammari, responsable du Programme National de Nutrition au ministère de la Santé, Mohammed Bengoumi, responsable de la production et de la santé animales au bureau de l’Organisation des Nations Unies pour l’Alimentation et l’Agriculture (FAO) au Maroc et Jaâfar Heikel, président de la Société Marocaine de Nutrition, Santé et Environnement. Les débats ont été modérés par Dr Ouafaa Fassi Fihri, Professeure de virologie, immunologie et maladies virales, et Dr Rajaa El Aouad, Professeure en Immunologie, spécialiste de la recherche biomédicale et en santé publique, respectivement présidente et vice-présidente de « One Health Maroc ». Pendant une heure et demie, les participants ont exposé leurs perspectives par rapport à ce sujet en essayant de trouver un terrain commun qui favoriserait la construction d’une synergie commune.
Convergence des efforts
« L’association « One Health Maroc » est certes mobilisée dans la promotion du concept « Une seule santé », mais elle reste une partie prenante qui représente la société civile. L’idéal serait d’amorcer une dynamique de convergence des efforts entre les divers départements concernés par la problématique, afin d’harmoniser les efforts dans le cadre d’une feuille de route globale. C’est pour cela que l’accent a été mis sur la collaboration multisectorielle lors du webinaire », nous confie Pr Ikhlass El Berbri, membre fondateur de l’association « One Health Maroc » et enseignante chercheuse au Département de Pathologie et Santé Publique Vétérinaire, à l’Institut Agronomique et Vétérinaire Hassan II. «À cet effet, le meilleur moyen serait de créer un comité interministériel qui puisse veiller à coordonner les efforts d’harmonisation des stratégies et de construire la bonne synergie », poursuit la même source.
Ampleur des enjeux
Alors que la pandémie de Coronavirus continue de sévir, l’importance d’une action structurée pour contrer et prévenir les risques sanitaires du même genre est plus évidente que jamais. « Il y a quelques années, était apparu le virus SRAS qui avait un taux de létalité important, mais qui était freiné par un potentiel de diffusion limité. Actuellement, on vit une pandémie causée par un virus dont le taux de létalité n’est pas vraiment important, mais qui fait énormément de dégâts parce qu’il a un grand potentiel de diffusion. La hantise des scientifiques est de voir émerger, dans les prochaines années, un virus qui combinerait un taux de létalité important avec une capacité de diffusion rapide », précise Pr El Berbri. Pour augmenter les chances de prévention d’un pareil monstre, chaque pays devra s’engager dans l’approche « One Health » qui décrit les moyens d’agir collectivement sur chaque maillon d’un cercle sanitaire vicieux. « Si les Etats au niveau mondial ne s’engagent pas dans des efforts de prévention et d’anticipation de ce genre de risque, les dégâts pourraient être phénoménaux quand un agent pathogène encore plus pernicieux que la Covid émergera », prévient Pr El Berbri.
Diverses perspectives
La table ronde virtuelle organisée par l’association « One Health Maroc » a été ainsi animée par des intervenants issus de divers domaines concernés par ce concept, avec, entre autres, Maryam Bigdeli, représentante de l’Organisation Mondiale de la Santé (OMS) au Maroc, Laila El Ammari, responsable du Programme National de Nutrition au ministère de la Santé, Mohammed Bengoumi, responsable de la production et de la santé animales au bureau de l’Organisation des Nations Unies pour l’Alimentation et l’Agriculture (FAO) au Maroc et Jaâfar Heikel, président de la Société Marocaine de Nutrition, Santé et Environnement. Les débats ont été modérés par Dr Ouafaa Fassi Fihri, Professeure de virologie, immunologie et maladies virales, et Dr Rajaa El Aouad, Professeure en Immunologie, spécialiste de la recherche biomédicale et en santé publique, respectivement présidente et vice-présidente de « One Health Maroc ». Pendant une heure et demie, les participants ont exposé leurs perspectives par rapport à ce sujet en essayant de trouver un terrain commun qui favoriserait la construction d’une synergie commune.
Convergence des efforts
« L’association « One Health Maroc » est certes mobilisée dans la promotion du concept « Une seule santé », mais elle reste une partie prenante qui représente la société civile. L’idéal serait d’amorcer une dynamique de convergence des efforts entre les divers départements concernés par la problématique, afin d’harmoniser les efforts dans le cadre d’une feuille de route globale. C’est pour cela que l’accent a été mis sur la collaboration multisectorielle lors du webinaire », nous confie Pr Ikhlass El Berbri, membre fondateur de l’association « One Health Maroc » et enseignante chercheuse au Département de Pathologie et Santé Publique Vétérinaire, à l’Institut Agronomique et Vétérinaire Hassan II. «À cet effet, le meilleur moyen serait de créer un comité interministériel qui puisse veiller à coordonner les efforts d’harmonisation des stratégies et de construire la bonne synergie », poursuit la même source.
Ampleur des enjeux
Alors que la pandémie de Coronavirus continue de sévir, l’importance d’une action structurée pour contrer et prévenir les risques sanitaires du même genre est plus évidente que jamais. « Il y a quelques années, était apparu le virus SRAS qui avait un taux de létalité important, mais qui était freiné par un potentiel de diffusion limité. Actuellement, on vit une pandémie causée par un virus dont le taux de létalité n’est pas vraiment important, mais qui fait énormément de dégâts parce qu’il a un grand potentiel de diffusion. La hantise des scientifiques est de voir émerger, dans les prochaines années, un virus qui combinerait un taux de létalité important avec une capacité de diffusion rapide », précise Pr El Berbri. Pour augmenter les chances de prévention d’un pareil monstre, chaque pays devra s’engager dans l’approche « One Health » qui décrit les moyens d’agir collectivement sur chaque maillon d’un cercle sanitaire vicieux. « Si les Etats au niveau mondial ne s’engagent pas dans des efforts de prévention et d’anticipation de ce genre de risque, les dégâts pourraient être phénoménaux quand un agent pathogène encore plus pernicieux que la Covid émergera », prévient Pr El Berbri.
Oussama ABAOUSS
3 questions au Pr Ikhlass El Berbri, microbiologiste
Ikhlass El Berbri
« 75% des maladies émergentes sont d’origine animale »
Enseignant chercheur au département de Pathologie et Santé Publique Vétérinaire, à l’Institut Agronomique et Vétérinaire Hassan II, Pr Ikhlass El Berbri a répondu à nos questions.
- Quels sont les indices qui démontrent une recrudescence des zoonoses dans le monde ?
- Depuis quelques décennies, une apparition et un développement de maladies, inconnues auparavant, ont été observés avec une fréquence inhabituelle. Le nombre d’évènements de ce genre a presque été multiplié par 4 en 50 ans. C’est ainsi que sont apparus des virus très pathogènes tels que : le SIDA, le SRAS, la grippe aviaire, Ebola, etc. Il est actuellement admis qu’en moyenne, 5 nouvelles maladies infectieuses chez l’Homme apparaissent chaque année, parmi lesquelles 3 sont d’origine animale, c’est-à-dire que 75% des maladies émergentes sont d’origine animale.
- Comment expliquer ce phénomène ?
- Le premier facteur est l’empiètement sur les habitats de la faune sauvage qui favorise la transmission de maladies animales vers l’Homme. D’autre part, le réchauffement climatique favorise la multiplication des pathogènes et des vecteurs de transmission des zoonoses, ce qui cause une augmentation des mutations et des risques que ces pathogènes puissent s’adapter à la physiologie humaine.
- Quelles sont les solutions qui permettront de limiter cette problématique ?
- La lutte contre le réchauffement climatique est un facteur déterminant. D’autre part, trois organisations mondiales ont conjugué leurs efforts afin de trouver la meilleure approche, à savoir le concept « One Health ». Quelques pays se sont déjà approprié cette approche. Cette dynamique est en train de se propager notamment au Maroc où nous avons commencé à travailler selon ce concept depuis 2010, surtout dans le domaine de la lutte contre la rage.
Enseignant chercheur au département de Pathologie et Santé Publique Vétérinaire, à l’Institut Agronomique et Vétérinaire Hassan II, Pr Ikhlass El Berbri a répondu à nos questions.
- Quels sont les indices qui démontrent une recrudescence des zoonoses dans le monde ?
- Depuis quelques décennies, une apparition et un développement de maladies, inconnues auparavant, ont été observés avec une fréquence inhabituelle. Le nombre d’évènements de ce genre a presque été multiplié par 4 en 50 ans. C’est ainsi que sont apparus des virus très pathogènes tels que : le SIDA, le SRAS, la grippe aviaire, Ebola, etc. Il est actuellement admis qu’en moyenne, 5 nouvelles maladies infectieuses chez l’Homme apparaissent chaque année, parmi lesquelles 3 sont d’origine animale, c’est-à-dire que 75% des maladies émergentes sont d’origine animale.
- Comment expliquer ce phénomène ?
- Le premier facteur est l’empiètement sur les habitats de la faune sauvage qui favorise la transmission de maladies animales vers l’Homme. D’autre part, le réchauffement climatique favorise la multiplication des pathogènes et des vecteurs de transmission des zoonoses, ce qui cause une augmentation des mutations et des risques que ces pathogènes puissent s’adapter à la physiologie humaine.
- Quelles sont les solutions qui permettront de limiter cette problématique ?
- La lutte contre le réchauffement climatique est un facteur déterminant. D’autre part, trois organisations mondiales ont conjugué leurs efforts afin de trouver la meilleure approche, à savoir le concept « One Health ». Quelques pays se sont déjà approprié cette approche. Cette dynamique est en train de se propager notamment au Maroc où nous avons commencé à travailler selon ce concept depuis 2010, surtout dans le domaine de la lutte contre la rage.
Recueillis par O. A.
Encadré
Antibiorésistance : Coordonner la lutte contre les germes résistants aux antibiotiques
Durant ces deux dernières décennies, l’Organisation Mondiale de la Santé a travaillé en étroite collaboration avec l’Organisation des Nations Unies pour l’Alimentation et l’Agriculture (FAO) et l’Organisation Mondiale de la Santé Animale (OIE) afin de promouvoir des réponses multisectorielles face aux risques alimentaires, aux risques issus des zoonoses et aux autres menaces pour la santé publique à l’interface homme-animal-écosystème. Ce travail conjoint a permis de dégager des orientations sur la façon de réduire ces risques et menaces. L’approche «One Health» s’applique à la conception et la mise en œuvre de programmes, de politiques, législations et travaux de recherche pour lesquels plusieurs secteurs communiquent et collaborent en vue d’améliorer les résultats en matière de santé publique. Elle est particulièrement pertinente dans les domaines de la sécurité sanitaire des aliments, de la lutte contre les zoonoses,mais également dans le domaine de la lutte contre la résistance aux antibiotiques (qui survient quand les bactéries changent après avoir été exposées aux antibiotiques et deviennent plus difficiles à traiter). Des microbes résistants aux médicaments peuvent se transmettre de l’Homme à l’animal et inversement, par contact direct entre les animaux et les humains ou par des aliments contaminés. C’est pour cette raison que le concept « One Health » joue aussi le rôle d’approche qui coordonne la lutte contre l’antibiorésistance aussi bien chez l’Homme que chez l’animal.
Repères
Une approche approuvée
L’approche « One Health » a été approuvée par plusieurs agences de l’ONU, la Commission Européenne, la Banque Mondiale, plusieurs universités, et bien d’autres institutions et organisations internationales. La FAO, l’OIE et l’OMS ont officiellement adopté cette approche en 2007, ce qui a permis au concept de prendre beaucoup d’ampleur depuis. Ces organisations ont même créé un guide visant à aider les pays à utiliser une approche « Une seule santé » dans la lutte contre les maladies zoonotiques.
« One Health Maroc »
L’association « One Health Maroc » a été créée en fin 2019 par un groupe de femmes issues de différentes spécialités suite à plusieurs travaux entrepris sur le terrain par chacune des membres-fondateurs. Le premier événement organisé par cette association a porté sur le sujet des maladies émergentes. Organisé le 7 février 2020 sous le thème « Les maladies émergentes selon le concept One Health », ce séminaire avait rassemblé plusieurs experts qui ont débattu des enjeux spécifiques liés à ces nouvelles maladies.